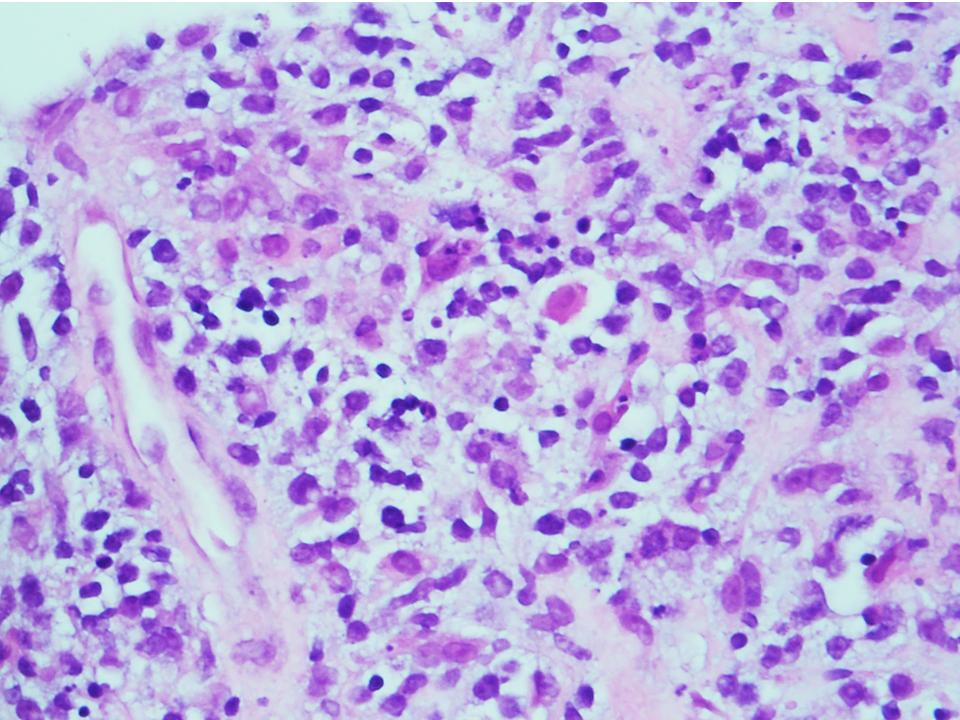
Siba El Hussein, MD tweet media
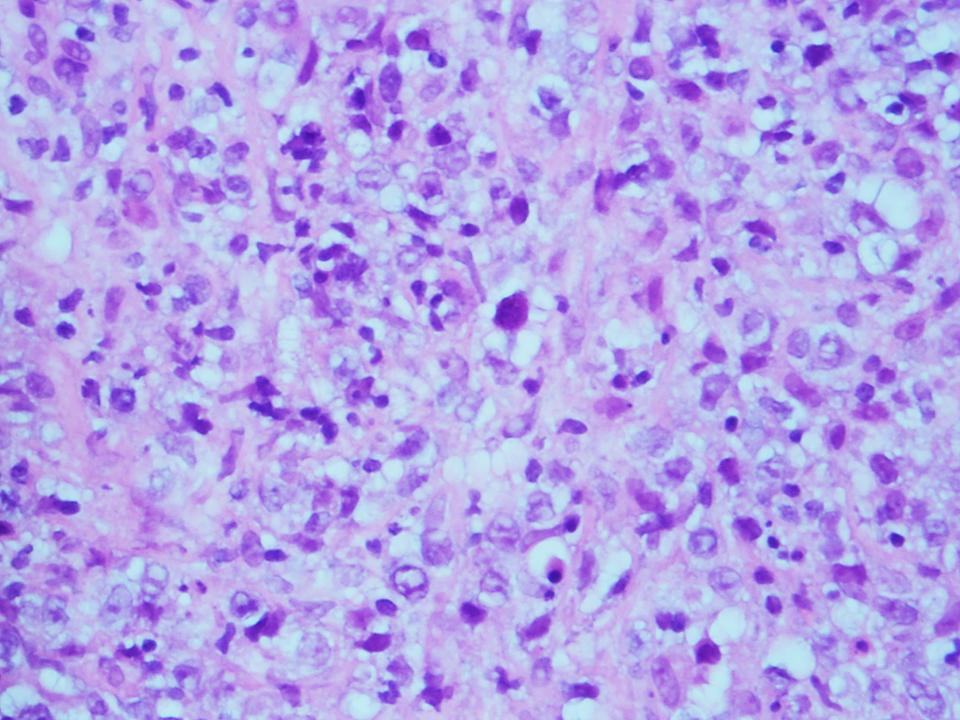
Siba El Hussein, MD tweet media

@KukMariya Myelolipomas are clonal. I published this a million years ago.
English
@Hemepathguy
1.3K posts

@hemepathguy
The real, former @DennisOMalleyMD. Opinions are NOW my own. Hematopathologist, #lymphoma, #heme, #spleen, guitar


Hey Pathology twitter! Thoughts?